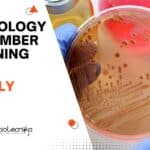
Microbiology Team Member Job Opening

Home Search
biology - search results
If you're not happy with the results, please do another search
Freshers Job Opportunity! BTech, MTech & MSc Biotech, Biochem & Microbiology Apply Online
Freshers Job Opportunity! BTech, MTech & MSc Biotech, Biochem & Microbiology Apply Online
Associate Content Editor - Chemical Patent Indexing (Bio)
Job Number: JREQ126504
City, ST: Hyderabad,...
PI Industries Team Leader Protein Engineering Post For Bioinformatics, Comp Bio, Structural Biology
PI Industries Team Leader Protein Engineering Post For Bioinformatics, Comp Bio, Structural Biology
Team Leader Protein Engineering
PI Industries Ltd · Udaipur, Rajasthan, India
About the job
The...
Jawaharlal Nehru University Molecular Biology Project Technician Job – Apply Now
JNU Mol Bio Project Technician Job - Apply Now
School of Biotechnology
Jawaharlal Nehru University
New Delhi – 110 067
Post: Project Technician
Applications are invited for the above...
PGIMER Microbiology Project Research Scientist (Non-Med) Job, Applications Invited
PGIMER Microbiology Project Research Scientist (Non-Med) Job, Applications Invited
DEPARTMENT OF MEDICAL MICROBIOLOGY
POSTGRADUATE INSTITUTE OF MEDICAL EDUCATION & RESEARCH, CHANDIGARH
NOTICE
Applications are invited for the posts...
CSIR-CCMB Biology Vacancies 2024 – Rs. 74,000 pm For Life Science – Apply Online
CSIR-CCMB Biology Vacancies 2024 - Life Sciences Candidates Apply Online
CSIR-CCMB Biology Vacancies 2024 - Life Sciences Candidates Apply Online. CSIR-CCMB Biology Vacancies 2024. Interested...
Microbiology NATCO Pharma QC Job Opening – Attend Walk-In-Interview
Microbiology NATCO Pharma QC Job Opening - Attend Walk-In-Interview
WALK-IN INTERVIEWS NATCO PHARMA LIMITED
10th March 2024 (Sunday)
Work Location: Nagarjuna Sagar
Position: Operator/Officers/Executive
Experience: 2 to 6 Years
NATCO
Department:...
Govt Silk Board CSRTI BSc Project Job Opening – Life Science, Zoology, Microbiology, Biochem...
Govt Silk Board CSRTI BSc Project Job Opening - Life Science, Zoology, Microbiology, Biochem Walk-In
CENTRAL SERICULTURAL RESEARCH AND TRAINING INSTITUTE
CENTRAL SILK BOARD, MIN.OF TEXTILES,...
Dr. Reddy’s Laboratories Hiring Biotech / Microbiology / Biochem For Team member – Drug...
Dr Reddy's Latest Biotech Job - Dr. Reddy’s Laboratories Ltd. is a leading multinational pharmaceutical company based across global locations. Each of their 24,000...
Microbiology Team Member Job Opening at Cipla – BSc Apply Online
Microbiology Team Member Job Opening at Cipla - BSc Apply Online
Junior Team Member - Microbiology
Requisition ID: 81466
Posted: 05/03/2024
Job Description
Division: Quality
Department: Quality
Employment Type: Permanent
Job Purpose
Execute...
Freshers Walk-In Drive at Lyfius Pharma (Aurobindo) For BSc / MSc/ BTech Biotech/Microbiology
Freshers Walk-In Drive at Lyfius Pharma (Aurobindo) For BSc / MSc/ BTech Biotech/Microbiology
AUROBINDO WALK-IN DRIVE
We are hiring Candidates for our Greenfield project LYFIUS PHARMA...
JNCASR MSc Biology Project Scientist Recruitment – Applications Invited
JNCASR MSc Biology Project Scientist Recruitment - Applications Invited
Jawaharlal Nehru Centre for Advanced Scientific Research
(An Autonomous Institute under Dept. of Science & Technology, Govt....
NIMHANS Research Scientist Job Opening With Rs. 56,000 pm For Molecular Biology
NIMHANS Research Scientist Job Opening With Rs. 56,000 pm For Molecular Biology
NATIONAL INSTITUTE OF MENTAL HEALTH AND NEURO SCIENCES
(INSTITUTE OF NATIONAL IMPORTANCE) BENGALURU-560029
No. NIMH/PROJ/ICMR/RM/1746/NOTI/2023-24...
BTech Biotechnology JRF Job Openings at CSIR-Indian Institute of Chemical Biology, Attend Walk-In
CSIR-IICB BTech Biotech JRF Job Openings - Attend Walk-In
Advertisement No.: R&C/573/2024
Date of Advertisement: 27/02/2024
Vacancy Code: 5732401
Position: JRF(GATE)
No. of Vacancies: 2
Walk-in Interview on: 21/03/2024
Reporting...
35+ Biology JRF Vacancies at CSIR-IICB – Attend Walk-In-Interview
CSIR-IICB Biology JRF Vacancies - Attend Walk-In-Interview
Advertisement No. : R&C/572/2024
Date of Advertisement: 27/02/2024
Vacancy Code: 5722401
Position: JRF (Direct)
No. of Vacancies: 55
Walk-in Interview on: 19/03/2024
Category...
Presidency University Biology Project JRF Job – Apply Now
Presidency University Biology Project JRF Job - Apply Now
Advertisement for a Junior Research Fellow position for a DSTBT Funded Project at the Institute of...